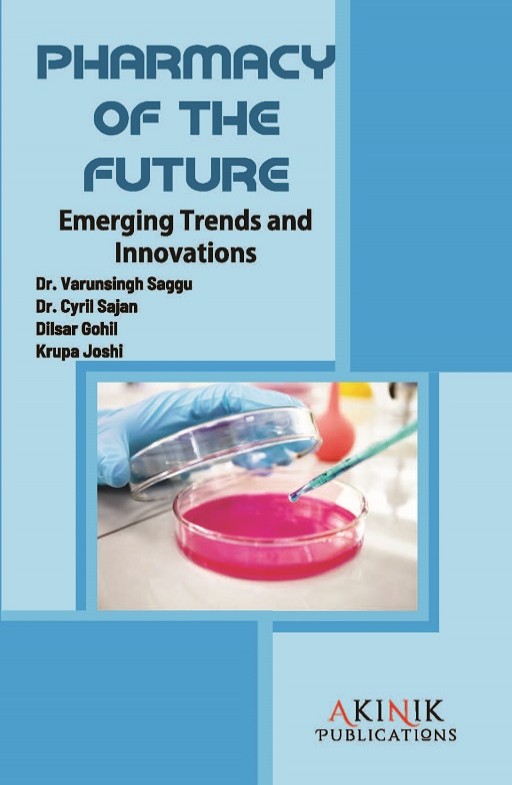
Pharmacy of the Future: Emerging Trends and Innovations

Description
Pharmacy of the Future: Emerging Trends and Innovations" is a comprehensive exploration of the rapidly evolving landscape of pharmaceutical sciences and healthcare. Authored by leading experts in the field, the book delves into cutting-edge advancements and transformative technologies that are shaping the future of pharmacy. The book covers a wide range of topics, including precision medicine, personalized drug therapies, the integration of artificial intelligence in drug discovery and patient care, innovative drug delivery systems, and the impact of genomics on pharmaceutical research. It provides a forward-looking perspective on how these emerging trends are reshaping the traditional role of pharmacists and revolutionizing patient outcomes.Readers will gain insights into the intersection of technology and healthcare, understanding how breakthroughs in areas like nanotechnology, telemedicine, and digital health are influencing the pharmaceutical industry. The book also addresses the challenges and ethical considerations associated with these innovations, ensuring a well-rounded exploration of the Pharmacy of the Future.Whether you're a healthcare professional, researcher, or simply interested in the future of medicine, this book serves as a valuable resource, offering a glimpse into the exciting developments that are poised to transform the field of pharmacy in the coming years.